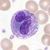
eosinofilní granulocyt

The final launch of the Allmultimedia.org will take place on February 24, 2026
(shortly after the 2026 Winter Olympics).
Krvetvorba
Z Multimediaexpo.cz
Krvetvorba (hematopoéza, hemopoéza, hemopoesa) je tvorba krevních buněčných komponent. Formované krevní elementy jsou diferencované a dále se již nedělí. Procesem krvetvorby se zajišťuje jejich neustálá obnova.
Obsah |
Vývoj krevních elementů
Zralé krevní elementy nemají schopnost se dělit (leckdy nemají ani jádro), proto se musí neustále obnovovat. Vznikající krevní element prochází stadiem proliferace (dělení), diferenciace a zrání.
Existují tři teorie vzniku krevních elementů:
- Monofyletická teorie: existuje jedna kmenová buňka, společná pro všechny typy krevních elementů
- Difyletická teorie: existuje kmenová buňka pro agranulocyty a jedna kmenová buňka, ze které se diferencují všechny ostatní krevní elementy
- Polyfyletická teorie: každý krevní element vzniká z vlastní kmenové buňky
V současnosti se jako nejpravděpodobnější jeví kompromisní teorie, podle které existuje jedna pluripotentní hematopoetická kmenová buňka (anglická zkratka: HSC), hemocytoblast, ze které se diferencují dvě buněčné linie, z jedné vznikají agranulocyty a z druhé ostatní krevní elementy.
Hemocytoblast je stabilní součást provazců hemopoetické tkáně ve stromatu červené kostní dřeně, mají vysokou mitotickou aktivitu. Dělením vznikají jak další hematopoetické kmenové buňky, tak buňky multipotentní.
Schema diferenciace jednotlivých krevních elementů
Obecné schéma:
- pluripotentní hematopoetická kmenová buňka (HSC) → multipotentní buňka → progenitorová buňka → prekurzorová buňka → plně diferencovaná buňka.
Vypadá to, že se vyskytují dva typy hematopoetických kmenových buněk[1] lišicí se vlastnostmi, ale v současnosti je nelze od sebe odlišit. Je dostupno pouze několik testů na odlišení primitivních a dlouhotrvajících kolonií buněk, které ale neposkytují důkaz o přítomnosti long-term stem cells.
- long-term stem cells - mají samoobnovovací schopnost, mohou plně obnovit krvetvorbu na déle než několik měsíců. Jsou důležité pro terapii.
- short-term stem cells nebo „prekurzorové buňky“ (anglicky: precursor cells) - mohou se dělit, ale po dlouhou dobu nemohou plně obnovovat samy sebe. Mohou se diferencovat do všech typů krevních buněk (prezkurorové pouze do jednoho typu buňky). Mohou obnovit krvetvorbu u myší pouze na dobu 3-4 měsíce a pro člověka to není známo (takové lidské buňky lze sice pokusně transplantovat myším, ale interpretace je sporná, protože člověk žije déle než myš). Podle rozdělení buněk v tomto článku se vlastně jedná asi o všechny typy hematopoetických buněk kromě nejpůvodnější pluripotentní hematopoetické kmenové buňky.
pluripotentní hematopoetická kmenová buňka / \ / \ / \ lymfoidní multipotentní buňka myeloidní multipotentní buňka | (CFU-GEMM myeloidní kmenová buňka) | | | | progenitorová buňka CFU-L progenitorová buňka | CFU-E CFU-GM CFU-Meg | / | \ \ | / | \ \ lymfoblast proerytroblast myeloblast monoblast megakaryoblast | | | CFU-M | | | | | | | | | | | prolymfocyt erytroblast promyelocyt promonocyt megakaryocyt | | | | | | | | | | | | | | | | retikulocyt myelocyt | | | | | | | | | | | | | | | | | | | metamyelocyt | | | | | | | | | | | | | | | | | lymfocyty erytrocyty granulocyty monocyty trombocyty
Linie myeloblastů jsou CFU-G, CFU-Eo, CFU-Bas.
- žlutě: buňky v kostní dřeni
- růžově: buňky v krvi
- hnědo-žlutě: T-lymfocyty v lymfatických uzlinách
- hnědo-oranžově: buňky v brzlíku
- oranžově: makrofágy ve tkáni
pluripotentní hematopoetická kmenová buňka myeloidní multipotentní buňka
(CFU-GEMM myeloidní kmenová buňka)
lymfoidní multipotentní buňka
(lymphoid stem cell)
BFU-E CFU-GM progenitorová buňka CFU-L CFU-E CFU-Meg CFU-M CFU-G CFU-Eo CFU-Bas pro-B cell subkortikální thymocyt basofilní erytroblast megakaryoblast neutrofilní myeloblast eosinofilní myeloblast bazofilní myeloblast pre-pre-B cell kortikální thymocyt polychromatofilní erytroblast neutrofilní promyelocyt eosinofilní promyelocyt bazofilní promyelocyt pre-B cell medulární thymocyt CD4+, medulární thymocyt CD8+ ortochromatický erytroblast neutrofilní myelocyt eosinofilní myelocyt bazofilní myelocyt early B cell supresorový T-lymfocyt, cytotoxický T-lymfocyt retikulocyt megakaryocyt promonocyt neutrofilní metamyelocyt eosinofilní metamyelocyt bazofilní metamyelocyt intermediate B cell erytrocyt
krevní destička monocyt
neutrofilní granulocyt
eosinofilní granulocyt
bazofilní granulocyt
B-lymfocyt
pomocný T-lymfocyt (pouze ze supresorových) NK buňka (LGL = large granular lymphocyte, null cell) makrofág aktivovaný B-lymfocyt
imunoblastaktivovaný T-lymfocyt aktivovaný makrofág lymfoplazmacytoidní buňka plasmatická buňka
Zkratky:[2]
- CFU = colony-forming unit
- CFU-GEMM =
- BFU-E = burst forming unit, (prekurzor erytrocytů)
- CFU-E = colony-forming unit erythrocyte
- CFU-Meg = CFU-Me = colony-forming unit megakaryocyte
- CFU-GM = colony-forming unit granulo-monocyte
- CFU-M = colony-forming unit monocyte
- CFU-G = colony-forming unit granulocyte
- CFU-Eo = colony-forming unit eosinophil
- CFU-Bas = colony-forming unit basophil
- CFU-L = colony-forming unit lymphocyte
- CFU-GEMM =
- LGL = large granuar lymphocyte
- NK = natural killer
Multipotentní buňky
Multipotentní buňky vznikají diferenciací pluripotentních kmenových buněk. Multipotentní buňky se dále dělí, dělením vznikají prekurzorové buňky i další multipotentní buňky.
Multipotentní buňky jsou dvojího druhu: lymfoidní a myeloidní. Část populace lymfoidních multipotentních buněk opouští kostní dřen a migruje do brzlíku, kde se dále diferencují na T-lymfocyty. Z buněk lymfoidní linie, které zůstaly v kostní dřeni, vzniknou B-lymfocyty.
Progenitorové buňky
Diferenciací multipotentních buněk vzniká další generace buněk, buňky progenitorové. Progenitorové buňky jsou stále schopné množit se a dát tak vznik dalším progenitorovým buňkám, na povrchu jejich membrám jsou ale receptory pro hemopoetiny, růstové faktory, které spouští diferenciaci buněk. Z progenitorových buněk jejich vlivem vznikají buňky prekursorové.
Prekursorové buňky
Prekursorové buňky svým dělením vytváření jen linii vedoucí ke zralému krevnímu elementu. Pro každý typ krvinky existuje jedna prekursorová buňka.
Erytropoéza, vznik červených krvinek
Červené krvinky jsou neplnohodnotné buňky, postrádající jádro. Vznikají diferenciací z prekursorové buňky, která se nazývá proerytroblast.
Proerytroblast | | Basofilní erytroblast | | Polychromatofilní erytroblast | | Ortochromatický erytroblast | | Retikulocyt | | Erytrocyt
Proerytroblast je buňka kulovitého tvaru, 15-20 μm velká. Dělením vznikají erytroblasty. U basofilního erytroblastu začíná syntéza hemoglobinu. U polychromatofilního erytroblastu je již v buňce tolik hemoglobinu, že cytoplasma ztrácí basofilii. Ortochromatický erytroblast se už dále nedělí. Vyvržením jádra mimo buňku (enukleace) vzniká z erytroblastu retikulocyt.
Retikulocyt je nezralá forma červených krvinek, která je už schopná plnit funkci erytrocytu. V oběhu je za normálních okolností určité množství retikulocytů, jejich podíl se může v případě nutnosti zvyšovat (např. krvácení). Za 3 dny retikulocyt uzraje ve zralou červenou krvinku.
Vývoj erytrocytů trvá asi 7 dní. Erytropoéza je ovlivňována hormony (erytropoetin, tyroxin, testosteron, estrogen, somatotropní hormon) a je při ní důležité železo, vitamín B12 a kyselina listová.
Leukopoéza, vznik bílých krvinek
Každý typ bílé krvinky vzniká ze samostatné prekursorové buňky. Lymfocyty jsou jediné krevní elementy, které vznikají diferenciací lymfoidní multipotentní buňky, ostatní bílé krvinky vznikají v myeloidní řady.
Lymfopoéza, vývoj lymfocytů
Část populace lymfoidních multipotentních buněk migruje do brzlíku, kde se dále diferencují na T-lymfocyty. Zbytek lymfoidní řady zůstává v kostní dřeni a dává vzniknout B-lymfocytům. B- a T-lymfocyty se od sebe liší jen povrchovými antigeny na buněčných membránách.
Prekursorovou buňkou je lymfoblast, ten se diferencuje na prolymfocyty. Ty se již dále nedělí a dozrávají v lymfocyty.
- lymfoblast → prolymfocyt → lymfocyt
Monocytopoéza, vznik monocytů
Prekursorovou buňkou pro monocyty je monoblast. Ten se diferencuje na promonocyty, které se dále dělí a diferencují se na zralé monocyty. Monocyty cirkulují v krvi asi 8 hodin, potom vstupují do vaziva, kde se mění v makrofágy.
- monoblast → promonocyt → monocyt
Granulopoéza, vývoj granulocytů
Granulocyty vznikají z prekursorových buněk, myeloblastů. Během diferenciace granulocytů jsou syntetizována specifická granula. U myelocytů již můžeme rozlišit typ vznikajícího granulocytu (neutrofilní, basofilní, eosinofilní). Metamyelocyt se již dále nedělí a dozrává v granulocyty. Granulopoéza je ovlivňována endotoxiny a glukokortikoidy.
- myeloblast → promyelocyt → myelocyt → metamyelocyt → granulocyt
PBStabkerniger.jpg
neutrofilní granulocyt |
Trombopoéza, vznik krevních destiček
Krevní destičky, trombocyty, nejsou buňkami, pouze fragmenty cytoplasmy obrovských buněk, megakaryocytů. Megakaryocyty se nacházejí v kostní dřeni. Vznikly z prekurzorové buňky, která se nazývá megakaryoblast.
Megakaryoblast → megakaryocyt → trombocyty
Prenatální a postnatální hematopoéza
Shrnutí
Při vývoji embrya začíná krvetvorba v krevních ostrůvcích ve žloutkovém váčku, pak v játrech a v oblasti zvané AGM (název pro myši) a nakonec v kostní dřeni.
Hematopoéza probíhá u (dospělého) člověka v myeloidní tkáni v kostní dřeni a v lymfatické tkáni v lymfatických uzlinách nebo ve slezině.
Obecně se dá prenatální krvetvorba rozdělit na tři pediody:
- Mezoblastová perioda - probíhá ve žloutkovém váčku embrya
- Hepatolienální perioda - probíhá v základu jater a sleziny
- Medulární (medulolymfatická) perioda - probíhá v kostní dřeni, lymfopoéza probíhá ve slezině a lymfatických uzlinách
Embryonální vývoj
16. den - tvorba krevních ostrůvků (to jsou shluky krevních buněk) ve žloutkovém váčku. V krevních ostrůvcích probíhá hematopoéza nejdříve. Primitivní erytrocyty (= megablasty) ve žloutkovém váčku syntetizují embryonální hemoglobin ξε.
Exprese CD34 na hematopoetických buňkách a na přilehlých endotelových buňkách. CD34 označuje předpokládaný hemangioblast v nediferencovaném žloutkovém váčku ještě dříve, než dojde ke tvorbě cév (tvorba cév = angiogeneze). (U křepelky se CD34 exprimuje nejprve na endotelových buňkách a z nich se vyvinou hematopoetické buňky.)
před 19. dnem nebyly nalezeny v embryu krevní buňky (= důkaz, že krevní buňky pocházejí ze žloutkového váčku a dostanou se do embrya až cirkulací)
19. den - splanchnopleura již obsahuje buňky, které se vyvinou na hematopoetické (intraembryonální) kmenové buňky (dokázáno na buněčných kulturách). Pouze kmenové buňky intraembryonálního původu (později ve vývoji) dávají vznik T a B lymfocytům, kolonizují játra ve „2. kolonizaci jater“ a zakládají trvalou hematopoézu.
19. den - nejvyšší frekvence krvetvorných endotelových buněk ve žloutkovém váčku.
21. den (3-somitové stadium) - začíná cirkulace krve a začíná fungovat oběhová soustava. 21. den - v srdeční dutině detekovány primitivní erytrocyty (megablasty) obsahující glykophorin A (= důkaz, že 21. den nastává cirkulace).
22. den (10-somitové stadium) - začátek vývoje jater. Játra netvoří hematopoetické progenitory, ale osídlují je hematopoetické buňky ze žloutkového váčku.
23. den (12-somitové stadium) - začátek krvetvorby v játrech (první kolonizace jater hematopoetickými kmenovými buňkami). Embrynální hemoglobin ξ je nahrazen fetálním hemoglobinem α. Embrynální hemoglobin ε je nahrazen fetálním hemoglobinem γ. Rozptýlené CD34 negativní buňky v játrech.
před 25. dnem potvrzeny ve žloutkovém váčku progenitory erythroidní a granulopoetické. Progenitory buněk jsou potvrzeny až už krev cirkuluje (cirkuluje od 21. dne), takže původ progenitorových buněk může být teoreticky jak ve žloutkovém váčku tak v embryu.
27. den - na vnitřní straně endotelu aorty se objevují hematopoetické buňky (aorta má v té době dvě části) a také roztroušeně v oblasti pupečníkových (umbilikálních) artérií arteriae umbilicales.
30. den - růst shluků hematopoetických buněk v aortě a jejich výskyt také v omfalomezenterické artérii arteria omphalomesentrica.
30. den - druhá kolonizace jater hematopoetickými kmenovými buňkami. CD34 (pozitivní) buňky potvrzeny v játrech.
4. týden - angio-hematopoetické progenitory Flk-1 a VEGF-R2 migrují ze splanchnopleury do subaortálního mezodermu.
4. týden - protein BB9 zjištěn na povrchu endotelových buněk aorty. Tento protein by mohl být prvním markerem hematopetických kmenových buněk (HSC) nebo hemangioblastu. (Protein BB9 mají na povrchu HSC v dospělé kostní dřeňi.)
4,5 týdne - ve žloutkovém váčku potvrzeny progenitory buněk CFU-GEMM, BFU-E, CFU-E a CFU-GM. Množství prgenitorů potom výrazně poklesne a úplně zmizí po 6. týdnu.
4,5 až 5. týden - pokles počtu magaloblastů v játrech. Ty jsou průběžně nahrazeny makrocyty.
35.-36. den - maximální rozvoj shluků hematopetických buněk v arteriích embrya.
5. týden - redukce počtu BFU-E ve žloutkovém váčku a zároveň vzestup počtu v játrech a v krevním řečišti
konec prvního trimestru a později - je detekováno více primitivních progenitorů CFU-GEMM a HPP-CFC (anglicky: high-proliferative colony forming cells)
40. den - po 40. dnu zmizí shluky hematopetických buněk v arterích
60. den - zmizení hematopoézy ve žloutkovém váčku
11. týden (od 10,5 týdne) - začíná krvetvorba v kostní dřeni ve specializovaných mezodermových strukturách (anglicky: primary logettes) v diafýze. První krevní buňky v kostní dřeňi jsou CD15+ myeloidní buňky a posléze také glykoforin A+ erytrocyty. (V kostní dřeňi nejsou CD34+ buňky.)
S vývojem kostní dřeně se tvoří postupně většina erytrocytů a granulocytů v kostní dřeni.
Později nastává krvetvorba ve slezině a lymfatických uzlinách. Tyto lymfoidní orgány postupně produkují většinu lymfocytů a monocytů, přestože lymfoidní progenitorové buňky pocházejí z kostní dřeně.
Většina krvetvorby probíhá u dospělců v kostní dřeni ve stehenní kosti a také v žebrech a hrudní kosti. Krvetvorba však může v případě nezbytnosti pokračovat také v játrech, brzlíku a slezině. Je to tzv. extramedulární = mimodřeňová hematopoéza. Může být příznakem závažných onemocnění, jako je leukémie.
Hematopoéza u myši domácí
Shrnutí:
Mezi 7-11 dnem se tvoří erythroidní a částečně také myeloidní (unipotentní) prekurzory ve žloutkovém váčku. Erytrocyty ze žloutkového váčku mají jádro (embryoblasty) a embryonální hemoglobin. Mezi 8,5-12,5 dnem se tvoří multipotentní HSC v oblasti zvané AGM, nejdříve v tzv. sub-aortic patches. Odtud teoreticky migrují do jater a odtud také teoreticky osidlují aortic clusters. Pak osidlují další krvetvorné orgány (brzlík, slezinu, kostní dřeň).
Chronologie:
- 7,5. den - začátek krvetvorby ve žloutkovém váčku. Žloutkový váček tvoří erythroidní a myeloidní linii. Není schopen (ani později) tvořit lymfoidní progenitory.
- 8. den - cirkulace krve mezi žloutkovým váčkem a tělem
Jak se vyvíjí krvetvorné oblasti uvnitř embrya:
- před 8. dnem - kaudální intraembryonální splanchnoleura (caudal intraembryonic splanchnoleura) (potvrzena lymfopoéza a v menší míře také myelopoéza) →
- → 8,5-10. den - anglicky: para-aortic splanchnopleura →
- → 10.-12. den - AGM. V AGM je aktivita CFU-S.
- 8,5-12,5. den - sub-aortic patches (= „sub-aortální plošky“) jsou na ventrální straně aorty a jsou umístěny přednostně pod aortic lusters. Lze je detekovat 10,5-11,5. den lépe než aortic clusters, protože sub-aortální plošky exprimují GATA-3 a AA4.1.
- 9. den - vznik jater jako výchlipka. Játra neiniciují krvetvorbu, ale jsou (stejně jako u člověka) kolonizovány a slouží jako rezervoár hematopoetických buněk vzniklých v dřívější fázi.
- 10. den (28-32 párů somitů) - kolonizace jater
- 10,5-11,5. den - aortic clusters (= „aortální shluky“) jsou na straně nejblíže coelomové dutiny, jsou vložené mezi endotelové buňky, např. na ventrální straně dorzální aorty. Exprimují CD34 a AA4.1 (podobně jako endotelové buňky, ale postrádají von Willebrandův faktor)
- 11. den (40-45 párů somitů) - kolonizace brzlíku
- 11. den - konec hematopoetické činnosti ve žloutkovém váčku
- po 12. dnu je brzlík již vždy lymfoidní
- 13. den - kolonizace sleziny pomocí HSC z jater krevním oběhem
- 15. den - hematopoetické buňky kolonizují kostní dřeň ihned, jakmile se objeví vaskularizace kostí. Ale jsou to progenitory pozdní fáze hematopoézy a uplatňují se až 4-5 dní po narození myši. Z nich vznikají linie pro dlouhodobou hematopoézu.
- (27. den - narození myši)
U myší hematopoetické aortic clusters exprimuje CD45 jenom několik buněk (na rozdíl od ptáků a lidí, kde jsou CD45+ všechny buňky v těchto aortálních shlucích).
Hematopoéza u obratlovců
Oblasti AGM (anglicky: aorta-gonad-mesonephros) u myši, ptačí embryonální aorta u ptáků a vnitřní strana endotelu aorty (společně s pupečníkovými a žloutkovými artériemi) u člověka jsou pravděpodobně homologické oblasti. Ale u člověka nebyla prokázána krvetvorná aktivita ve (vyvíjejících se) gonádách a ledvinách.
U některých obratlovců může při nedostatečném zásobení krví probíhat krvetvorba také ve střevě, slezině, ledvinách nebo vaječnících.
Výzkumem na modelových organizmech na ptácích a myších přibližně v letech 1995-2005 se zjistilo, že základní pravidla krvetvorby platí shodně pro všechny vyšší obratlovce. Tzn., že ve žloutkovém váčku se tvoří HSC pro primární krvetvorbu a v embryu (v AGM) se tvoří HSC pro definitivní krvetvorbu.
U obojživelníků platí to samé, ale u některých (např. Xenopus laevis) se zdá, že lymfopoéza závisí na prekurzorech z obou oblastí.
Reference
- ↑ Chapter 5: Hematopoietic Stem Cells (Poslední změna: Friday, August 12, 2005.) - Stem Cells: Scientific Progress and Future Research Directions. Department of Health and Human Services. June 2001. http://stemcells.nih.gov/info/scireport.
- ↑ Seznam CD a schéma vývoje krevních elementů, (firma Serotec), citováno 2005-12-07, (PDF)
Související články
Literatura
- Dzierzak E., Medvinsky A. & Bruijn M. de: Qualitative and quantitative aspects of haematopoietic cell development in the mammalian embryo. - Immunology Today, 19(5): 228-236 (1998).
- Godin I. & Cumano A.: Of birds and mice: hematopoietic stem cell development. - Int. J. Dev. Biol. 49: 251-257 (2005).
- Tavian M. & Péault B.: Embryonic development of the human hematopoietic system. - Int. J. Dev. Biol. 49: 243-250 (2005).
- Histologie: Cytologie a obecná histologie, Fakulta veterinárního lékařství, Brno 2000
Externí odkazy
- Tulane (anglicky)
| Náklady na energie a provoz naší encyklopedie prudce vzrostly. Potřebujeme vaši podporu... Kolik ?? To je na Vás. Náš FIO účet — 2500575897 / 2010 |
|---|
| Informace o článku.
Článek je převzat z Wikipedie, otevřené encyklopedie, do které přispívají dobrovolníci z celého světa. |